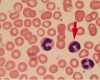
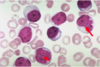

White Blood Cells and Lymph nodes, Part 1 Flashcards
what is leukopenia?
how do you see leukopenia in a lab report?
what is the most affected cell?
what else may cause leukopenia?
what causes lymphopenia?
decrease in number of circulating white blood cells
WBC = less than 4,000
neutrophils
lymphopenia
occurs due to whole body radiation, imunodeficiency (HIV, DiGeorge), corticosteroids
Neutropenia & Agranulocytosis
what can cause neutropenia? what causes these?
1) Inadequate or ineffective granulopoeisis
* Suppression of hematopoeitic stem cells: Aplastic anemia, and marrow infiltration (tumors and granulomatous dis)
* Suppression of committed granulocytic precursors: due to drugs (most common cause)
* Diseases associated with ineffective hematopoeisis: Megaloblastic anemia, MDS
* Rare congenital diseases: kostmann’s syndrome
2) Accelerated removal or destruction of neutrophils
* Immunologically mediated: SLE
* Splenomegaly: splenic sequestration
* Increased peripheral utilization: bacterial, fungal, rickettsia
what is neutropenia in a lab report?
what is mild neutropenia?
what is moderate neutropenia?
what is severe neutropenia?
what is agranylocytosis?
less than 1500
1000-1500
500-1000
less than 500
less than 100
how do you confirm neutropenia and agranulocytosis?
total WBC = reduced
peripheral blood smear = neutropenia
absolut neutrophil count = reduced
bone marrow: hypocellular if drug induced
hypercellular when there is increased peripheral destruction of neutrophils
what is noticible in this picture?

absence of neutrophils
what can be noticed here?

hypocellularity of the bone marrow
when do you know there is a serious infection?
what are some examples of secondary infections to agranulocytosis?
what is the treatment for these conditions
when neutrophil count drops below 500
infections:
1) ulcerating necrotizing lesions of : gingiva, floor of mouth, buccal mucosa
2) severe life threatening infections: lungs, kidney deep fungal infections: Candida and Aspergillus
Treatment:
granulocytic transfusions using recombinant granulocyte growth factors: G- CSF, GM- CSF
what is this?

Candida albicans of oral mucosa
what are 2 types of proliferative disorders that are reactive (or inflammatory)?
1) leukocytosis
2) lymphadenitis
what are the 2 division types of lymphadenitis?
1) acute non-specific lymphadenitis
2) chronic non-specific lymphadenitis
what is 1 type of proliferative disorder that is neoplastic?
1) Neoplastic Proliferation of White cells
what is the normal white cell count for adults?
what is the normal range for these in adults:
neutrophils
lymphocytes
monocytes
eosinophils
basophils
4000-11000
neutrophils: 40-70%
lymphocytes: 20-40%
monocytes: 1-8%
eosinophils: 1-6%
basophils: 1%
what are the 2 special types of leukocytosis?
1) leukemoid reaction
2) Leukoerythroblastic reaction
what is a leukemoid reaction?
what appears in a peripheral smear with this condition?
when could the white count be higher?
some inflammatory states or chronic infections cause the total white cell count to be elevated (WBC more than 50000)
immature granulocytes
chronic myelogenous leukemia (CML)
how do you differentiate between CML and leukemoid reaction?
unsing a LAP score (leukocyte alkaline phosphatase):
- increased in Leukemoid reaction
- low in chronic myeloid leukemia (CML)
what is a left shift?

red cell clumping due to preparation, not pathological
what is this?
‘band’ neutrophils in peripheral smear
what is this?

Neutrophil metamyelocyte in peripheral smear
what is Leukoerythroblastic reaction?
what is its pathogenesis?
what do you see in a peripheral smear?
- immature granulocytes and eryhtroid precursors enter peripheral blood
- bone marrow infiltration (amyloidosis, Gaucher’s,
leukemias, metastatic cancers)
- marrow fibrosis occurs
you see immature granulocytes, and nucleated red cells
what do you see in this peripheral blood smear?

Leukoerythroblastic reaction
note: numerous nucleated red cells (red arrow and immature granulocytes-white cells (green arrow)
what do you see in this peripheral smear?

Leukoerythroblastic reaction: blood smear showing neutrophils, immature granulocytes, lymphocytes, and nucleated red cell.
where do you see toxic granulations?
how do you identify them?
in severe infections with sepsis
neutrophils contain numerous dark purple granules
what is this?

toxic granulation
what is the first thing you think when you hear lymphocytosis?
viral infection
when are Döhle bodies?
how do you identify them?
seen along with toxic granulations
light blue smudge within mature neutrophils
what is this?

Döhle bodies
what is this?

dohle body
what is the pathogenesis of leukocytosis?
- size of the precursor pool (BM, thymus, circulation, peripheral tissues)
- rate of release of cells from storage pools into circulation
- proportion of cells that are adherent to blood vessel wall (marginal pool)
- rate of extravasation of cells from blood into tissues
what are the causes of leukocytosis?
1) Increased production in the marrow
2) Increased rate of release from BM
3) Decreased margination
4) Decreased extravasation
what causes leukocytosis due to increased production in the bone marrow?
- chronic infection/inflammation (IL-1, TNF)
- paraneoplastic (Hodgkin lymphoma)
- myeloproliferative disorders (CML)
what causes leukocytosis due to increased rate of release from Bone Marrow?
- endotoxemia (sepsis)
- infection
- hypoxia
what causes leukocytosis due to decreased margination?
- exercise
- catecholamines
what causes leukocytosis due to decreased extravasation?
glucocorticoids
mononucleosis is an example of what?
what are the symptomes?
on who does it happen?
lymphocytosis
fever, pharyngitis and lymphadenopathy
young adolescent
what is the pathology of mononucleosis?
how does the immune system react against these B cells affected?
EBV transmits through body fluids and infects usually tonsils (infects B cells expressing CD21)
the infection does 1 of 2 things?
1) infects and causes lysis
2) remains latent in B cells and expresses 2 proteins:
- EBNA1: to bind EBV to chromosome
- EBNA2 and LMP1: to turn on B cell proliferation
- The activated B cell goes around the body secreting antibodies
The immune system uses CD8 and natural killers to go against the infected B cells
what are these?
downey cells
what can we expect in a lab report for these values under mononucleosis?
CBC
Peripheral blood smear
lymph node
lab investigation
CBC = WBC increased
Peripheral blood smear = downey cells (atypical lymphocytes)
lymph node = paracortical lymphoid hyperplasia
lab investigation = positive antiviral capsid antigen test (monospot test)
what if a monospot appears negative in a patient who has infectious mononucleosis?
What are the clinical features of infectious mononucleosis?
patients with infectious mononucleosis are at increased risk of what?
the person actually will have CMV
clinical features:
fever, lymphadenopathy, pharyngitis, rash (when treated with ampicillin), fatigue/malaise, splenomegaly
increased risk of splenic rupture
what is this?

lymphadenitis
Lymphadenitis is what?
how are these lymph nodes related to cancer?
how is lymphadenitis evaluated?
enlargement of the lymph nodes
non-cancerous or no neoplasia seen
evaluation:
FNAC
imprint
Immunohistochemistry
Electron Microscopy
Flow cytometry
Molecular diagnosis
what is this?

lymphadenopathy
what is this? what type?

Acute non-specific lymphadenitis
what are the 2 types of lymphadenitis?
1) Acute non-specific lymphadenitis
2) Chronic Non-specific Lymphadenitis
when do you see acute non-specific lymphadenitis?
how do you know is acute?
this type of lymphadenitis involves what area most commonly?
what type of lymphadenitis can mimic appendicitis?
what infections can cause generalized lymphadenitis?
when there are reactive changes in lymph nodes when they are presented with: microbiologic agents, cell debris and foreign bodies.
because there is reddening
anterior cervical lymph nodes (tonsils, dental) and inguinal
acute mesenteric lymphadenitis
systemic viral infections in children and bacteremia
in acute non-specific lymphadenitis, how will the lymph nodes look grossly?
in acute non-specific lymphadenitis, how will the lymph nodes affected look under the microscope?
centers of follicle will show what?
lymph nodes are enlarged
prominent lymphoid follicles containing large germinal centers and macrophages containing particulate debris are seen
necrosis when there is pyogenic organisms
what is this?

acute non-specific lymphadenitis
A) Numerous follicles containing paler appearing germinal centers.
what is this?

Acute non specific lymphadenitis
B) Lymphoid follicle containing numerous pale appearing macrophages
what are the clinical features of acute non-specific lymphadenitis?
in actue non-specific lymphadenitis, what is very important about the clinical features? why?
Clinical features:
- lymph nodes enlargement
- tender on palpation, due to distension of lymph node capsule
- overlying skin is inflamed
location is very important
- Occipital Ln: scalp infection
- Pre-auricular Ln: conjunctival infections, cat-scratch disease
- Posterior cervical Ln: toxoplasmosis
- Inguinal Ln: STD’s
what are the 3 types of chronic non-specific lymphadenitis?
Types:
- Follicular Hyperplasia
- Paracortical Hyperplasia
- Sinus Histiocytosis
what causes follicular hyperplasia?
what can be seen on microscopy of chronic non-specific lymphadenitis?
what can be said about the lymph node’s structure?
activation of humoral immune responses
formation of “secondary follicle”: a large round to oblong B- cell rich germinal centers surrounded by a collar of resting B lymphocytes (mantle zone) also lymph node contains macrophages containing nuclear debris (numerous phagocytosed apoptotic bodies)– “tingible body macrophages
the lymph node’s structure remains intact
what is this?

follicular hyperplasia
what is this?

follicular hyperplasia
note: reactive follicle, surrounded by mantle zone (green arrow)
what is this?

Tingible body macrophages
tingible body macrophages found in chronic non-specific lymphadenitis of follicular type can be associated to what diseases?
rheumatoid arthritis, toxoplasmosis, early stages of HIV
what is this?

tingible body macrophages
what is seen here?
follicular hyperplasia
what causes paracortical lymphoid hyperplasia in chronic non-specific lymphadenitis?
what can be noted about the morphology of lymph node in paracortical lymphoid hyperplasia?
Paracortical lymphoid hyperplasia will be associated with what?
- activation of cellular immune responses
- reactive changes involve T- cell region (interdigitating dendritic cells, histiocytes)
- there is exapansion of the paracortica/interfollicular regions
- there is presence of immunoblasts (activated T-lymphocytes)
- hypertrophy of sinusoidal and vascular endothelial cells
will be associated with:
- immunologic reactions induced by drugs (Dilantin)
- acute viral infections (infectious mononucleosis)
- vaccination against certain viruses
what can be noted with sinus histiocytosis in the morphology of the lymph node?
sinus histiocytosis can be seen with what diseases?
- there will be characteristic distension and prominence of lymphoid sinusoids
- hypertrophied endothelial cells lining lymph sinuses
- increase in number of macrophages
Clincally:
associated with lymph node draining cancers
what can be seen here?
when is this seen?

widening of lymphatic sinusoids
sinus histiocytosis
what is seen here?

sinus histiocytosis
types of lymph node metastasis?
- Submental: metastases from squamous cell ca. floor of the mouth
- Cervical: head & neck tumors
- Virchow’s node (left supraclavicular): stomach, pancreas cancers
- Axillary: breast cancers
- Hilar: lung cancers
- Mediastinal: lung cancers, Hodgkin lymphoma (nodular sclerosing), T- cell ALL
- Para-aortic: testicular, Burkitt lymphoma
- Inguinal: vulva, penis cancers


